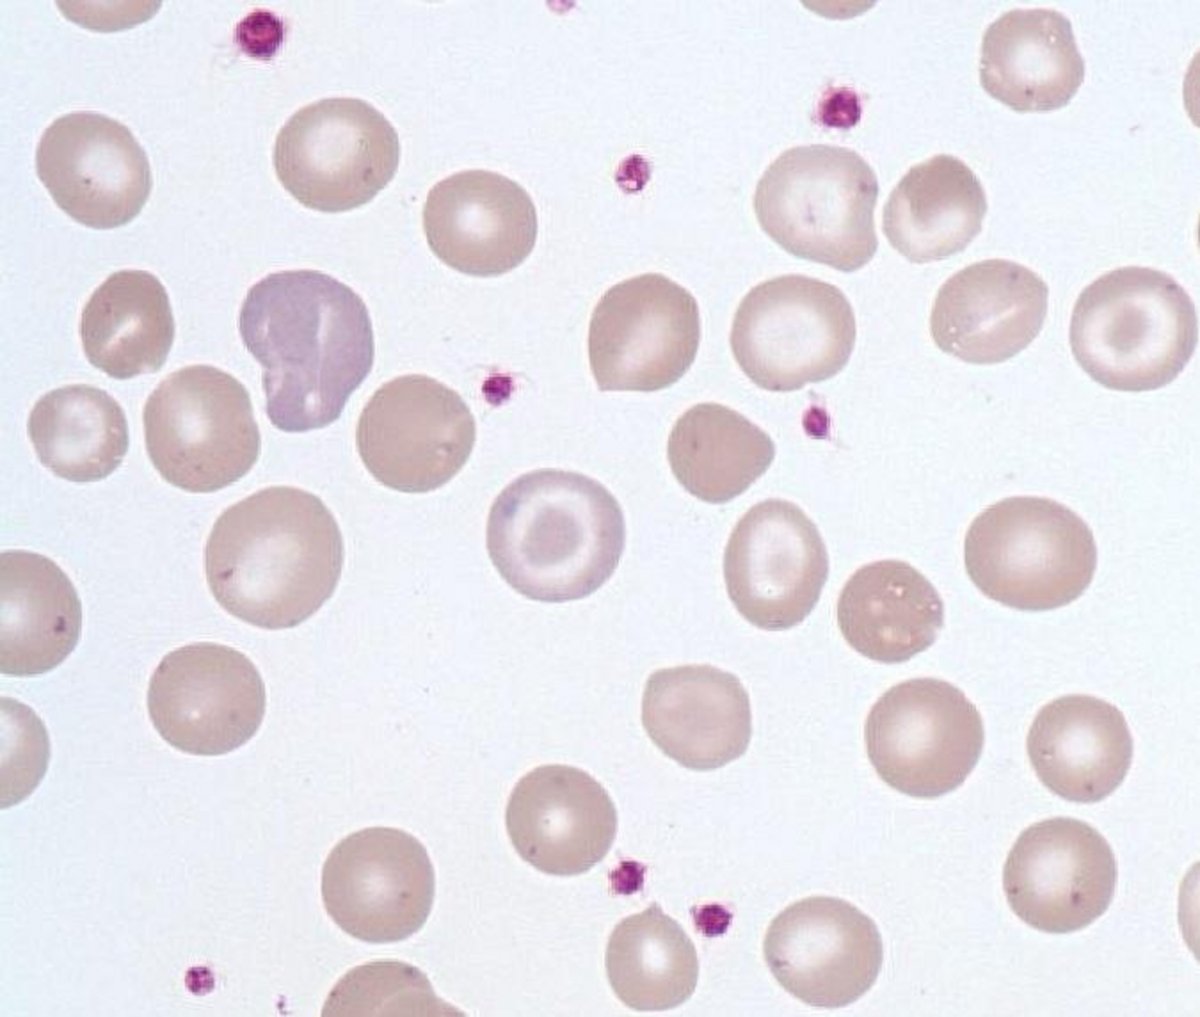
Target_cell

Target cell
- Size : about 1 RBC
- Normal values : Absent in the blood
- Description / Pathology :
Red blood cell with three concentric area reflecting normal concentration Hb zones (center and periphery) and low concentration Hb zone (intermediate clear zone).
Thalassemia.